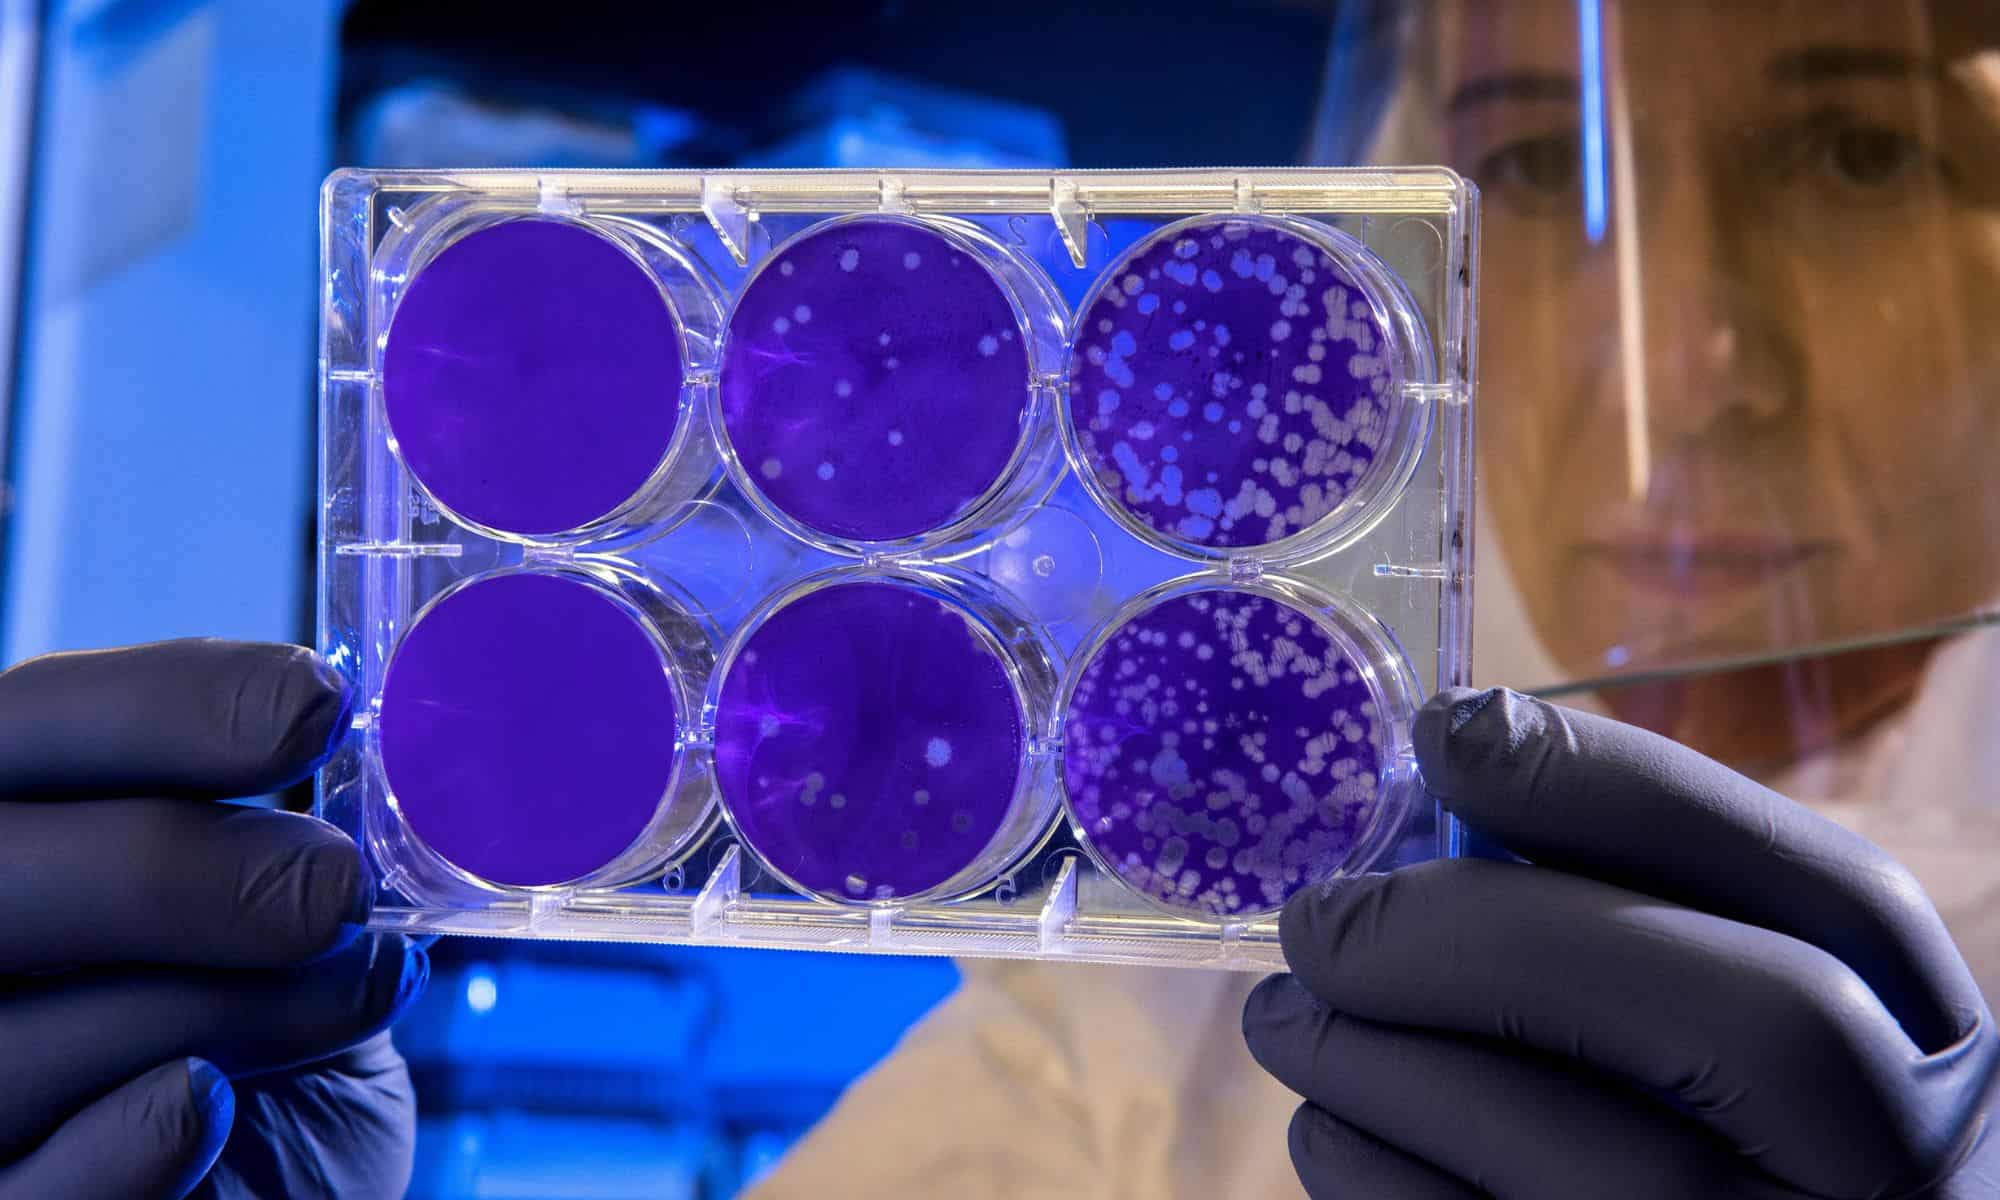

The invisible influencer
Biological assays are a vital part of modern research and drug discovery, yet their reproducibility is still a persistent challenge.  Rachel Sully explores how material factors play a critical role, and how integrating these can lead to more reliable data.
An integral part of research and development is the use of biological assays, also known as bioassays, to evaluate the biological activity of substances. A biological assay is designed to quantify the potency or concentration of a substance by measuring its effect on a living organism or biological system. These assays are used to evaluate a wide range of compounds, including drugs, hormones, toxins, growth factors and environmental contaminants; and help researchers better understand the pharmacological properties, toxicity and therapeutic potential of substances.
Materials science provides the platforms, tools and novel materials that enhance assay performance, sensitivity and speed of biological assays.
From microfluidic chips to nanoparticles, creating highly specialised environments for detecting and analysing biological assays enhances their sensitivity and speed. However, advances in synthetic surfaces used for assays have created new challenges.
Surface chemistry controls the interactions at interfaces of biological assays to manage specific binding of proteins and cells, preventing non-specific binding (fouling), which is crucial for assay sensitivity, specificity and reproducibility. Surface chemistry is focused on the chemical processes that occur on or in the vicinity of a surface, which usually is also at the interface between distinct phases, such as solid-liquid or solid-gas surfaces.

In everyday life, surface chemistry is prevalent, for example, in catalytic converters in vehicles, which turns harmful exhaust gases into less harmful substances by reactions on solid surfaces.
In biological assays, surface chemistry affects cell adhesion and plays a key role in immobilisation of assays, anti- fouling techniques, signal enhancement and compatibility. Many assays involve the immobilisation of a molecule to the assay surface for detection. Therefore, understanding the surface chemistry of your detection molecule can influence the capture molecules chosen when designing the assay. Other materials, such as polyethylene glycol (PEG), are used to prevent fouling of unwanted biomolecules or cells, reducing background noise of assays. Also tailoring the surface properties of the detector molecules can enhance signal – for example altering the surface charge of a nanoparticle, or hydrophilicity of a material.
Different surface functionalisation strategies can affect the immobilisation, stability and activity of detector molecules, which in turn determines biological assay quality and effectiveness. Microarrays are used widely in research as they allow high-throughput analysis of proteins or DNA. However, their performance strongly depends on how well capture molecules are immobilised on the sensing surface. Optimising the surface chemistry of biological assays is key for improving their sensitivity, reproducibility, and reliability across different assay formats.
Another major factor to consider when developing or optimising biological assays is the interfacial tension of the components. This tension is present at an interface between two adjacent phases which do not completely mix – these unbalanced forces at the surface of separation cause interfacial tension. In biological assays, the interfacial tension directly influences how liquids interact with solid assay surfaces and with each other. The main factors include wetting, spreading and retention of reagents, which in turn affect the binding efficiency and signal uniformity, causing assay variability.
Surface chemistry controls the interactions at interfaces of biological assays to manage specific binding of proteins and cells
High interfacial tension can cause poor wetting, limiting the contact area between analyses and immobilised capture molecules, while lower interfacial tension promotes spreading and more efficient binding. As assays become miniaturised, interfacial tension has a greater effect on the biological assay. For example, in microfluidic devices, the fluid flow is controlled by the capillary forces which are driven by the interfacial tension. Therefore, small variations in surface energy or fluid composition produce significant differences in assay behaviour, making interfacial tension a critical design parameter for microfluidic systems.
Microstructure refers to the small-scale, microscopic arrangement, distribution and morphology of the biological materials or associated components within an assay system. This internal organisation significantly influences the assay’s performance, function and the material’s biological properties. In tissue or cell culture assays, the organisation of the cells and presence/distribution of pores within these structures is the microstructure. The way in which these tissues or cells are organised affects the cell attachment, proliferation and function, all of which can have a significant effect on an assay. Therefore, understanding and characterising the microstructure is crucial in biological assays to link the physical arrangement of the components to the desired biological or chemical performance and reliability of the system.
Designing miniature environments – such as microfluidic chips, scaffolds, microcells, etc. – enable faster and more sensitive testing of substances by controlling with high precision the cell behaviour and function, biomaterial interaction and molecular detection. The mimicking of physiological conditions within these miniature environments can be used to assess drug effects, toxicity and environmental responses. These miniature environments also reduce sample volumes, in turn increasing throughput of an assay and its sensitivity. Microfluidics specifically allow for precise fluid control and microstructures such as scaffolds can mimic the body, facilitating the study of how cells and tissues interact or degrade.

Biological assays are sensitive to material and interfacial effects that extend beyond biological variables alone. As discussed, surface chemistry, interfacial tension and microstructure play significant roles in controlling biomolecular interactions, non- specific binding, wetting behaviour and cellular responses. Uncontrolled surfaces and interfaces are major contributors to assay variability, while well-engineered chemistries and interfaces improve sensitivity, specificity and reproducibility by stabilising biomolecule immobilisation, reducing fouling and ensuring consistent signal generation. Ultimately, improving reproducibility in biological assays requires integrating materials science principles into assay design and reporting. Systematic control and characterisation of surface properties, interfacial behaviour and microstructure are essential factors when optimising and developing robust, reliable and translatable biological assays.
Biological assays are an integral part of research and development to evaluate the biological activity of substances and therefore need to have strong credibility. However, a big challenge of biological assays is their reproducibility by other scientists – over 70% of researchers were unable to reproduce other scientists’ findings, and 60% were unable to reproduce their own. This could be due to a multitude of factors such as inappropriate study design including use of contaminated or over-passages cell lines, bias, non- publication of negative results, inability to manage complex data sets and insufficient descriptions of methods.
So, what can we do, as scientists, to increase reproducibility of studies? Through significant efforts to identify areas of policy that can be changed, a set of practices have been recommended:
- Robust sharing of data, materials, software and other tools – all raw data of a published article should be readily available.
- Use of authenticated biomaterials – low- passage reference materials verified by multifaceted approaches to confirm phenotypic and genotypic traits, and a lack of contaminants is essential.
- Training on statistical methods and study design – adhering to a set of best practices in statistical methodology and experimental design can boost validity and reproducibility of work.
- Pre-registration of scientific studies.
- Publishing of negative data – helps others to interpret positive results from related studies and helps researchers adjust their experimental designs.
- Thorough description of methods – clearly report key experimental parameters.
There are many organisations already working to improve reproducibility of scientific research such as the ASCB report on Reproducibility; NIH’s Rigor and Reproducibility; and the COS/Science Exchange’s The Reproducibility Project: Cancer Biology. However, more responsibility needs to be taken by the scientific community, with individuals acting and seeking opportunities for improvement to improve research practices and the credibility of scientific data.
The performance and reproducibility of biological assays are strongly affected by surface chemistry, interfacial tension and microstructure, alongside biological variables. By integrating materials science principles with reproducibility initiatives, biological assays can be produced that are more reliable, robust and translatable across research settings.
References:
Chiodi, E et al. The Role of Surface Chemistry in the Efficacy of Protein and DNA Microarrays for Label-Free Detection: An Overview. Polymers 2021, 13, 1026 https://pmc.ncbi.nlm.nih.gov/articles/PMC8036480/pdf/polymers-13-01026.pdf
Morgan, A. Understanding the Influence of Surface Tension in Microfluidic Systems. Fluid Mech Open Acc 10 (2023): 273 https://www.hilarispublisher.com/open-access/ understanding-the-influence-of-surface-tension-in-microfluidic-systems.pdf
ATCC. Six Factors Affecting Reproducibility in Life Science Research and How to Handle Them. Nature Portfolio. Accessed 2 January 2026 https://www.nature.com/articles/d42473-019-00004-y#ref-CR2
Dr Rachel Sully is a senior formulation chemist




